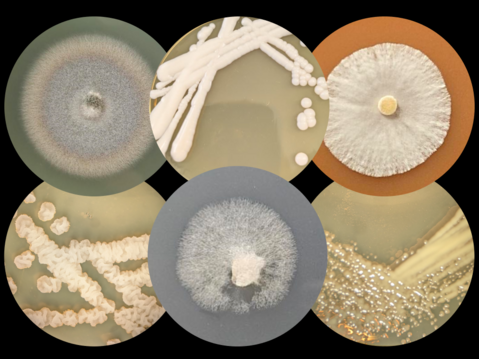

Institute of Microbiology and Microbial Biotechnology
Mission Statement
The IMMB investigates microorganisms of relevance to industry and the environment. We study their genetics, cell biology and metabolism with state of the art systems and synthetic biology methods, and engineer them for better performance in industrial bioprocesses.

Metabolic Engineering and Process Design
Diethard Mattanovich
- Metabolic Engineering
- Cell and Process Engineering
- Genome Diversity
Industrial Microbiology
Martin Altvater - Anna Maria Erian
- Microbial Chemical Production
- Biodiversity
- Strain Engineering
- Membrane Transport

Yeast Molecular Biotechnology
Brigitte Gasser
- Protein production and secretion with yeasts esp. Pichia pastoris
- Systems and synthetic biology
- Promoter, cell and redox engineering

Metabolic modeling and cell engineering
Özge Ata
- C1-based metabolic and process engineering
- Synthetic pathway and metabolism redesign
- Metabolic flux analysis
- Regulation of cellular carbon and energy metabolism
BioArt Revolution
An exhibition with BOKU-EU project VIVALDI participation highlighting groundbreaking milestones in microbiology, science and technology through art in Timişoara, the European Capital of Culture 2023.
BioArt Revolution | Revoluția BioArt is an innovative solo exhibition and program of events by internationally renowned British artist Anna Dumitriu, who has collaborated with researchers at the University of Natural Resources and Life Sciences Vienna. The exhibition brings together contemporary artistic approaches and modern scientific experiments to address global issues such as infections, climate change and biodiversity.
The exhibition is part of the official events program of Timișoara, the European Capital of Culture 2023, and demonstrates the power of international collaboration in the fields of art and science. BioArt Revolution | Revoluția BioArt is organized in partnership with the Romanian Science Festival Romania, the country's first national science festival, and the Austrian agency sonja schachinger proper partner KG.
The title of the exhibition, BioArt Revolution | Revoluția BioArt, alludes to the historical events of 1989, when the spark of revolution ignited in Timișoara and led to the fall of communism in Romania. Today, we stand on the threshold of another revolution - one driven by rapid scientific advances. Anna Dumitriu's work offers a fresh perspective on how these technologies will shape our future, often drawing inspiration from the history of science.
The exhibition ANNA DUMITRIU: BioArt Revolution is part of the official program of the European Capital of Culture Timişoara 2023, which opened on September 19, 2023 and will be on display until October 1.
Management and Administration
Addresses & Contact
Institute of Microbiology and Microbial Biotechnology
DBT/IMMB
Muthgasse 18/V
1190 Wien
Contact:
https://boku.ac.at/btlw/immb
Tel.: +43 1 47654 79002
Fax: +43 1 47654 79009
dbl(at)boku.ac.at








